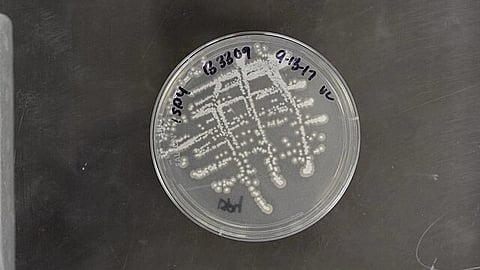
Streptomyces, a gene of bacteria that is the source of the majority of antibiotics of natural origin (Wikimedia Commons)

The entire biosynthetic pathway of actinopyridazone has been unveiled, revealing that an unprecedented carrier protein-mediated ring-forming step is key to its synthesis.
Nitrogen–nitrogen bond-containing cyclic compounds such as pyrazole, triazole, pyridazine and many others are critical building blocks for a variety of medicinal compounds, both natural and synthetic. The biosynthesis of some of these compounds hinges on the formation of nitrogen–nitrogen (N–N) single bonds between amino acids. However, the mechanisms by which a diversity of compounds is possible are poorly understood.
Dr Kenichi Matsuda and Professor Toshiyuki Wakimoto at Hokkaido University led a team to elucidate the biosynthetic pathway of actinopyridazinone, an N–N bond-containing cyclic compound that is an important scaffold for synthetic drugs. Their findings were published in the journal Angewandte Chemie International Edition.
“Actinopyridazinone is produced by Streptomyces, a genus of bacteria that is the source of the majority of antibiotics of natural origin,” Wakimoto explains.
In previous work, the team used bioinformatics to identify a group of gene sequences that are potentially involved in the biosynthesis of natural products that contain N–N bonds, and from these genome sequences, they discovered the novel class of compounds called actinopyradizones. With a series of genetic and biochemical experiments, they were also able to unveil the first steps in the pathway; in this study, they focused on understanding how the dihydropyridazone ring is formed.
The gene cluster apy is the biosynthetic gene cluster associated with actinopyradizone synthesis. It contains 17 potential genes; knockout studies indicated that ten of these—apy1, apy2, apy3, apy4, apy6, apy8, apy9, apy10, apy11 and apy13—were necessary for actinopyradizone synthesis. Biochemical analyses of the knockouts allowed the team to deduce that Apy3, an AMP-dependent synthetase/ligase, Apy4, a serine hydrolase, and Apy6, a carrier protein-rhodanese fusion, were the key proteins responsible for the formation of the dihydropyridazone ring.
“Apy6 functions as a carrier molecule; and Apy3 loads the intermediate compound onto Apy6,” Matsuda elaborates. Apy4 then catalyses the removal of an acetyl group (–COCH3); the resulting molecule is unstable and spontaneously reacts to form a dihydropyridazone ring.
Matsuda said that this study is the first description of the biosynthetic pathway for actinopyradizone, and is only the second study to report the enzyme-dependent biosynthesis of a N–N bond-containing ring structure. The first such compound is piperazic acid, whose biosynthetic pathways are completely unrelated; hence, this study has also highlighted that the biosynthetic pathways of N–N bond-containing cyclic compounds are very diverse. (SS/NW)